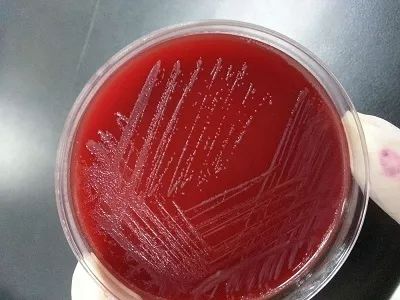
阴道炎复发率高,阴道炎老是复发喝中药能好吗

来源:恩哥聊健康 作者:邹世恩
小梅33岁,结婚多年,有一个可爱的孩子和爱她的丈夫。然而,从一年多之前开始,每隔两三个月,她就要得一次阴道炎,明显地影响生活和工作。经常为了看病请假,老板都开始意见。
第一次发作时,是念珠菌性阴道炎,白带像豆腐渣样,外阴和阴道痒得不得了。医生用药后,很快就好了。但是,两个月后又出现阴道痒,念珠菌性阴道炎复发了,还同时查出细菌性的阴道病。
之后就像中了魔咒,每两三月就要发作一次。有几次,医生问到:你丈夫包皮长吗?有没有包茎?说多了,小梅也开始怀疑起来,回家特地抓着丈夫检查了一下,还真是包皮过长!
割!必须得割!
三十好几的丈夫,只好去了泌尿科。人家医生一句话:你这包皮很容易翻出来,洗干净就行,不用割!
男人本来就好面子,加上医生给的勇气。回到家,丈夫就怼了回去:不关我的事儿!你自己关注点卫生!
小梅心里别提多委屈,自己每天勤洗澡洗外阴,每天换*裤内**,也没有不良的生活习惯,凭什么说我不讲卫生!

诊室里,听完小梅的叙述,我给她支了几招:
预防阴道炎复发,首先是要彻底地规范治疗!
阴道炎可以根据感染的病原体进行分类,常见的是有滴虫、念珠菌、细菌或混合感染等。不管何种病原体感染,用药治疗都需要用够天数,再巩固足够疗程。
有一些病人,用药两三天,症状消失了,想着抗菌药不能多用,就自己停药。却是不知道,这样恰恰给相对耐药的病菌机会,敏感的病菌死的差不多了,没有竞争对手,耐药病菌就开始疯狂生长,夜夜笙歌。下次再发病,就没那么容易灭菌了。
用够天数,症状治愈之后,一般建议连着两个周期,月经干净后复查,必要时还需要用药巩固治疗。
阴道炎用药的天数和巩固疗程都是根据病原体特点制定的,这样才能达到彻底治疗的目的。正所谓“宜将剩勇追穷寇,不可沽名学霸王”!
其次,增强自身健康状况
人体和病原体既共存,又有对抗!两者之间存在平衡,一旦身体健康状况下降,抵抗力弱了,病菌就会占据上风,继而出现各种感染症状。
阴道炎也是如此。正常情况下,阴道里以乳酸菌为主,混杂好多病原体,却可以相安无事,不引起炎症。这都有赖于阴道壁的物理抵御能力以及各类免疫细胞和因子、阴道酸碱度等综合作用。
如果这些抵抗的力量减弱了,比如绝经后缺乏雌激素,阴道壁的粘膜变薄,抵抗力就削弱了;如AIDS患者或长期使用免疫*制剂抑**等免疫力低下者;作息紊乱、不运动、营养不良等等,也会让人体的抵抗力下降。
有则改之,无则加勉。
还要去除易感因素
阴道微环境的平衡一旦被打破,就可能出现炎症。常见的易感因素有这些:
1、 阴道冲洗:好多人把阴道冲洗当做护理常规,时不时来一下。殊不知每次冲洗都打破阴道微环境的平衡,反而增加阴道炎的风险。即使真正阴道炎症,冲洗也不是常规的治疗方法,治疗还是以抗菌药为主。
2、 频繁*生活性**:每次*生活性**之后,阴道的微环境都会发生改变,当然,阴道也有自己调整的能力。如果频率太多,就可能发炎。这个度可以自己掌握,没有明确规定。每次*生活性**之后,最好能够及时起来排尿并清洗外阴。
3、 孕妇或糖尿病血糖控制不好:会让阴道里糖原增加,改变pH值,所以这两类人群也相对容易患阴道炎。
4、 大热天穿牛仔裤、化纤*裤内**等,容易造成会阴部潮湿,滋长病菌。尽量避免。
5、 超重:见过很多胖妹妹,外阴发湿疹,因为容易出汗,会阴部经常潮湿。所以,控制体重也可能解决一部分复发性阴道炎的病人。
6、 丈夫包皮过长、包茎:如果能够外翻并每天清洗干净,每次全程戴套,应该会好一点。否则,需要好好治治!
7、 贴身*裤内**或卫生巾出状况:*裤内**至少每天一换,有条件者3-4月更换新的*裤内**;卫生巾或棉条根据实际情况数小时一换。但是,每天换下来的*裤内**可能会沾染各种分泌物和寄生的病菌,即使是洗干净的*裤内**还含有大量的细菌。我们即将面临梅雨季节,潮湿的空气加上缺乏阳光曝晒,很容易助长病原体的生长。所以,这个季节也是阴道炎高发的时间。

听完这些,小梅意识到自己应该是错怪老公,回去更换*裤内**,以后做好*裤内**的清洁和消毒。我叮嘱她,先用药治疗,用药过程及后续还有问题,可以关注“恩哥聊健康”,在公众号后台留言咨询。
欢迎您加入我们的微信群:请加管理员微信linchuangkuakao,请务必标注您的专业、学历、职称!